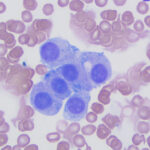

Interpretation
Malignant tumor with endocrine or neuroendocrine features (Question 1)
Explanation
The sample was highly cellular, consisting of neoplastic cells arranged in variably sized, frequently dense, aggregates, some of which were intercalated with red blood cells (Figure 2a), but many aggregates appeared cohesive (Figure 2b-d). Individualized cells were also seen in low numbers (Figure 2d). Numerous closely-associated groups of ruptured bare nuclei were also seen, which is a feature of endocrine or neuroendocrine tumors (Figure 2e). Individualized cells were round to oval with eccentric round to oval nuclei and moderate amounts of medium blue cytoplasm (Figure 2b-d, f). The cells had stippled chromatin and indistinct nucleoli. They displayed mild to moderate anisokaryosis, but individualized cells with macronuclei (intact and ruptured) were seen. In several smears, cells contained low numbers of blue-green granules, typically at the periphery of the cells near the cytoplasmic margins (Figure 2f). Cytoplasmic margins varied from indistinct (in thicker groupings) to distinct in smaller groupings and more individualized cells. A few cells in the aggregates and more individualized cells had moderate amounts of pink-red granules in their cytoplasm (secretory product, presumptive) (Figure 2c). A small amount of the material was also seen between cells in some of the aggregates (not shown). Overall, the results indicated a tumor with features supportive of a neuroendocrine tumor, which was likely metastatic (Question 1). The primary site for the tumor was unclear at the time the smears of the splenic aspirate were assessed. Endocrine or neuroendocrine tumors are rare in the spleen and the specific tumor type could not be ascertained from the smears. A differential diagnosis was a carcinoma of unknown primary origin. The smears did not contain cytologic evidence of a metastatic mast cell tumor (Question 2).
Follow up
Approximately one month later, the dog was returned by the owners to CUVS for computerized tomographic analysis. The analysis revealed a large mass located in the deep tissues of the upper cervical region, which was suspected to be associated with the carotid artery or body or both (Figure 3a-b). The appearance of the thyroid glands was unremarkable. Small brain lesions (Figure 3a) and pulmonary nodules were also noted. Splenic nodules were still present (Figure 3c).
Fine-needle aspirates were collected from the upper cervical mass in the region of the carotid body and smears were submitted for cytologic evaluation (Figures 4a and 4b).

Modified Wright-stained smears of the mass in the region of the carotid body were composed of small clusters and packets of round to oval cells with numerous bare nuclei from ruptured cells in the background. The cells displayed moderate anisocytosis and anisokaryosis and contained pale to medium blue slightly grainy cytoplasm. The nuclei were round to oval and paracentral to eccentric with finely stippled chromatin and 1-2 round indistinct nucleoli. Low numbers of cells had blue-green granules in the cytoplasm, usually at the edge of the cell, and rare cells had pink-red cytoplasmic granules. Considering the location of the mass, the cytologic interpretation was a chemodectoma. The cells identified in the smears of the splenic aspirate performed earlier displayed similar cytologic characteristics to this newly diagnosed tumor near the carotid body (Figure 5). Therefore, the cells in the spleen likely reflected metastasis of the chemodectoma in the neck, which was only identified when imaging was done for staging of the previously diagnosed metastatic mast cell tumor.
Outcome
Given the extensive nature of the upper cervical mass in the region of the carotid body and the presence of multiple presumed additional metastatic lesions (lungs, brain), surgery was not recommended. Treatment with Palladia® was offered and ultimately elected by the owners. The dog is still currently being treated at the time of this report.
Discussion
Chemodectomas are neuroendocrine tumors that are a subset of extra-adrenal paragangliomas that arise from nonchromaffin chemoreceptor cells in the carotid, aortic, jugular, or vagal bodies.1 Rare forms develop from the glomus pulmonale, a region containing chemoreceptors at the bifurcation of the pulmonary artery2 or within the heart (e.g. the fold between the interatrial septum primum and secundum). The latter tumors are postulated to arise from cells that move from the neural crest into cardiac locations during fetal life.3 Chemodectomas are encountered more frequently in dogs than in other domestic species, such as cats, cattle, or horses.4 Prior reports cite a higher prevalence in brachycephalic dogs, such as Boxers, Boston Terriers and French Bulldogs, attributing oncogenesis to their predisposition to hypoxia, which causes chronic stimulation of the chemoreceptors.5,6
Chemodectomas are locally invasive, but are considered to mostly have benign behavior, with infrequent metastasis. In one study with 11 confirmed cases of heart-based likely aortic body chemodectomas, distant metastasis occurred in two cases (18%).7 Metastatic lesions have been detected in the liver, bone, lungs, brain, kidney, and eye,6–11 with intracardiac metastases reported in two dogs.12,13 It has been theorized that malignant chemodectomas tend to be large and multilobular,6 however, the most consistent indicators of malignancy are metastasis to regional lymph nodes or distant organs and vascular invasion, instead of cytologic or histologic features, such as anisokaryosis (as seen in our case). There are only a few reports of metastatic aortic body-based chemodectomas to the spleen in dogs11 with two reports of splenic metastases of abdominal extra-adrenal chromaffin paragangliomas in horses.14,15 In this case and a previous report of a chemodectoma in the superior choroid of a right eye of a dog,10 the metastatic lesion was identified 1-9 months before the primary tumor was uncovered. This data suggests that advanced imaging, such as computerized tomography or magnetic resonance imaging, should be performed to locate the primary tumor in dogs when neuroendocrine tumors are identified in a presumed metastatic location.
Affected dogs with chemodectomas are typically older (median or mean of 10 years, range 4-123 years).16-18 Clinical signs and complications are mostly due to invasion and compression of local structures19 or are non-specific, including lethargy and exercise intolerance.7,16 However, many dogs show no clinical signs and the tumor is an incidental finding during echocardiographic evaluation or other imaging,3,7 as seen in this case, where the primary tumor in the cervical region was found on computerized tomography for mast cell tumor staging. If located in the carotid body, the tumor can invade lymphatic or blood vessels (e.g. external jugular vein) and the vagus nerve or completely envelop these vital structures. Large masses can result in gagging or swallowing abnormalities.7,16 When located in the aortic body, the tumor can compress the atria, partially surround great vessels at the base of the heart, infiltrate the pulmonary artery or atria, and displace the trachea. Dogs with carotid and aortic body tumors can exhibit respiratory clinical signs, such as dyspnea or cough, as well as acute collapse, syncope or even sudden death from compression of vital structures.7,17,20 Dogs with heart-based tumors can be presented with clinical signs of cardiac disease, including pleural effusion, pericardial effusion, murmers and arrythmias.7,16,19
Cytologically, it can be challenging to differentiate chemodectomas from other endocrine or neuroendocrine tumors, such as ectopic thyroid tumors,21 which can also be found in the same location as chemodectomas.7,21 Smears of aspirates tend to be highly cellular and rupture readily with smear preparation, yielding a characteristic bare nuclei appearance of neuroendocrine or endocrine neoplasms. Individualized large nuclei can be seen in some cases.22 When intact, the cells can be arranged in clusters or individually. The cytoplasm is described as basophilic23 or “eosinophilic granular”.22 The cells can contain a variable amount of pink granular material in their cytoplasm,23 which is also described in cytologic smears of all extra-adrenal paragangliomas in a seven-case series in humans.24 These cytologic characteristics were also observed in our case, although only a few cells contained red-pink cytoplasmic granules and we did see small amounts of similarly colored extracellular material, which could represent matrix. We have seen blue-green granules at the periphery of tumor cells in chromaffin- and non-chromaffin extra-adrenal paragangliomas and other endocrine tumors, e.g. gastrinomas (unpublished observations). Intranuclear cytoplasmic pseudo-inclusions have been described in chemodectomas in a single case report in a dog22 and 3/7 cases in humans.24 Additional features described in the report in humans were acini formation, spindled cells, visible nucleoli, and cytoplasmic vacuoles.24 Several tumor cells in this case also had cytoplasmic vacuoles. Spindled cells and chondroid metaplasia were seen in an aortic body tumor, deemed a carcinoma based on lung metastasis, in another report from a dog. The tumor had neurosecretory granules on electron microscopy and was positive on immunostaining for neuroendocrine markers (see below).25
A definitive diagnosis of chemodectoma can be achieved using histopathologic evaluation of tissue biopsies or resections combined with immunohistochemical staining for neuroendocrine markers. The tumor is generally composed of sheets of polygonal to round cells, forming cords or packets, supported by a fibrovascular stroma. The cells have discrete borders, granular eosinophilic cytoplasm, and round nucleoli.26 Silver stains, such as Grimelius and Churukian Schenk, will reveal an argyrophilic reaction in the tumor cells, indicating a neuroendocrine origin.27,28 Immunohistochemical staining is fundamental in the diagnosis of this neoplasm, allowing the identification of cytoplasmic neurosecretory and dense core granules that demonstrate positive staining for synaptophysin, neuron-specific enolase, and chromogranin A, which are considered the most specific markers (Question 3). The tumors can express S-100, but immunostaining for this calcium-binding protein can be positive in other tumors, such as melanoma. Neuroendocrine tumors, unlike thyroid or parathyroid tumors, are usually negative for pancytokeratin, which is a helpful immunostain to further differentiate between endocrine or neuroendocrine tumors in the neck region, cranial thorax or mediastinum. However, the aortic body carcinoma described above was unexpectedly positive for pancytokeratin, along with synaptophysin and chromogranin A.25 On transmission electron microscopy, cells in these tumors contain intracytoplasmic electron-dense neurosecretory granules.17,22,29
Surgical resection of chemodectomas is challenging and may not be achievable due to location or local invasion in and around vital structures. Surgery can also be used to alleviate clinical signs, e.g. pericardiectomy for cardiac tamponade, with a positive outcome on survival.16,30 Radiation is a relatively safe alternative that can delay the need for a pericardiectomy with heart-based tumors.31 In one study of 26 dogs with heart-based tumors treated with stereotactic radiation, the median survival was 404 days with partial response or stable disease in 85% of treated patients. Seven of the tumors were confirmed to be chemodectomas.7 More advanced techniques, such as ultrasound-guided radiofrequency ablation, have yielded promising results, with immediate relief of clinical signs, albeit in five dogs.18 Dogs can also be given chemotherapy, with toceranib phosphate being the current drug of choice. In a multi-institutional retrospective study of 27 dogs with aortic body tumors (21 presumptive and 6 confirmed chemodectomas), 89% of treated dogs achieved partial or total remission, or stabilization of the disease for more than 10 weeks, with a median survival time of 478 versus 521 days if given concurrent adjunctive therapy (e.g. radiation, non-steroidal anti-inflammatory drugs, pericardiectomy, or chlorambucil).16
Various tumors can metastasize to the spleen including carcinomas, mesenchymal tumors (e.g. osteosarcoma), and round cell tumors (e.g. mast cell tumors). The presence of an endocrine or neuroendocrine tumor in the spleen is rare, with only two cases being identified in 262 post-mortem samples; these were single cases of phaeochromocytoma and chemodectoma.32 The other reports are metastatic lesions from extra-adrenal paragangliomas7,11,14,15 or adrenal tumors.33 In this case, given the history of a high-grade mast cell tumor that had been previously resected, a metastatic mast cell tumor was the main differential diagnoses for the splenic nodules detected on ultrasonographic examination. Indeed, metastases of the mast cell tumor were identified in the aspirates of the right medial iliac lymph node, despite the two-year time frame between detection of these new lesions and resection and chemotherapy of the primary tumor. It is possible that the chemodectoma was present at the time the dog was diagnosed with a mast cell tumor and treated with toceranib, which may have impacted growth of this second occult neoplasm. Regardless, the chemodectoma ultimately metastasized to the spleen, with a diagnosis of two different metastatic tumors being made at the time of re-assessment.
Author: Laura Quishpe Contreras (resident), Brittany Zumbo (CUVS oncologist), T. Stokol
Acknowledgements: The authors thank Dr. Alison Tarbell for providing the computerized tomographic images and Dr. Samantha Evans, the clinical pathologist who first examined the medial iliac lymph nodes and splenic smears.
References
- Walsh MF, Cadoo K, Salo-Mullen EE, Dubard-Gault M, Stadler ZK, Offit K. 13 – Genetic Factors: Hereditary Cancer Predisposition Syndromes. In: Niederhuber JE, Armitage JO, Kastan MB, Doroshow JH, Tepper JE, editors. Abeloff’s Clinical Oncology (Sixth Edition). Sixth Edition. Philadelphia: Elsevier; 2020. p. 180-208.e11. Available from: https://www.sciencedirect.com/science/article/pii/B978032347674400013X
- Saunders R, Kraipowich N, Marshall HC. Intracardiac malignant nonchromaffin paraganglioma (chemodectoma) in a cat. J Vet Cardiol. 2021 Oct 1;37:1–7.
- Bussadori C. 18 – Cardiac Tumors. In: Madron É de, Chetboul V, Bussadori C, editors. Clinical Echocardiography of the Dog and Cat [Internet]. St. Louis: Elsevier Masson; 2015. p. 271–82. Available from: https://www.sciencedirect.com/science/article/pii/B9780323316507000181
- Yates WD, Lester SJ, Mills JH. Chemoreceptor tumors diagnosed at the Western College of Veterinary Medicine 1967-1979. Can Vet J. 1980 Apr;21(4):124–9.
- Henry CJ, Higginbotham ML, editors. Chapter 21 – Tumors of the Thoracic Cavity. In: Cancer Management in Small Animal Practice. Saint Louis: W.B. Saunders; 2010. p. 231–48. Available from: https://www.sciencedirect.com/science/article/pii/B9781416031833100213
- Miller MA. Chapter 12 – Endocrine System. In: Zachary JF, editor. Pathologic Basis of Veterinary Disease (Sixth Edition). Sixth Edition. Mosby; 2017. p. 682-723.e1. Available from: https://www.sciencedirect.com/science/article/pii/B9780323357753000126
- Kruckman-Gatesy CR, Ames MK, Griffin LR, Boss MK, Rao S, Leary D, et al. A retrospective analysis of stereotactic body radiation therapy for canine heart base tumors: 26 cases. J Vet Cardiol. 2020 Feb 1;27:62–77.
- Szczech GM, Blevins WE, Carlton WW, Cutlan GR. Chemodectoma with Metastasis to Bone in a Dog. J Am Vet Med Assoc. 1973 Mar 1;162(5):376–8.
- Bandinelli MB, Viezzer Bianchi M, Wronski JG, Santos de Mello L, Blanco DeMartini R, Savi C, et al. Ophthalmopathologic characterization of multicentric or metastatic neoplasms with an extraocular origin in dogs and cats. Vet Ophthalmology. 2020;23(5):814–27.
- Lucyshyn DR, Knickelbein KE, Hollingsworth SR, Reilly CM, Brust KD, Visser LC, et al. Choroidal neuroendocrine neoplasia in a dog. Vet Ophthalmology. 2021;24(3):301–7.
- Gliatto JM, Crawford MA, Snider TG, Pechman R. Multiple organ metastasis of an aortic body tumor in a boxer. J Am Vet Med Assoc. 1987 Nov 1;191(9):1110–2.
- Cho KO, Park NY, Park IC, Kang BK, Onuma M. Metastatic Intracavitary Cardiac Aortic Body Tumor in a Dog. J Vet Med Sci. 1998;60(11):1251–3.
- Crawford-Jennings MI, Chavez LD, Loessberg ER, Carvallo-Chaigneau FR. Aortic body tumor with intracardiac metastasis in a dog. J Vet Diagn Invest. 2025 Jan 7;10406387241304438.
- Kim DY, Hodgin EC, Lopez MK, Nasarre C. Malignant Retroperitoneal Paraganglioma in a Horse. J Comp Pathol. 1994 May 1;110(4):407–11.
- Herbach N, Breuer W, Hermanns W. Metastatic Extra-Adrenal Sympathetic Paraganglioma in a Horse. J Comp Pathol. 2010 Aug 1;143(2):199–202.
- Coto GM, Musser ML, Tropf MA, Ward JL, Seo YJ, Mochel JP, et al. A Multi-Institutional Retrospective Analysis of Toceranib Phosphate for Presumed or Confirmed Canine Aortic Body Chemodectomas. Front Vet Sci. 2021 Feb 5;8:635057.
- Noszczyk-Nowak A, Nowak M, Paslawska U, Atamaniuk W, Nicpon J. Cases with manifestation of chemodectoma diagnosed in dogs in Department of Internal Diseases with Horses, Dogs and Cats Clinic, Veterinary Medicine Faculty, University of Environmental and Life Sciences, Wroclaw, Poland. Acta Vet Scand. 2010 May 22;52(1):35.
- Gómez Ochoa P, Alférez MD, de Blas I, Fernendes T, Sánchez Salguero X, Balañá B, et al. Ultrasound-Guided Radiofrequency Ablation of Chemodectomas in Five Dogs. Animals (Basel). 2021 Sept 24;11(10):2790.
- Mincă NA, Dumbravă IC, Tudor N, Ștefănescu A, Vițălaru AB, Ioniță L, et al. Review on the Clinical, Imaging, and Therapeutic Aspects of Cardiac Masses in Dog. Life (Basel). 2025 July 11;15(7):1092.
- Harms NJ, Guest BB, Allen AL. Investigating the sudden death of a dog. Can Vet J. 2010 Feb;51(2):210–2.
- Friedrichs KR, Young KM. 7 – Diagnostic Cytopathology in Clinical Oncology. In: Withrow SJ, Vail DM, Page RL, editors. Withrow and MacEwen’s Small Animal Clinical Oncology (Fifth Edition) [Internet]. Fifth Edition. Saint Louis: W.B. Saunders; 2013. p. 111–30. Available from: https://www.sciencedirect.com/science/article/pii/B9781437723625000074.
- Romanucci M, Malatesta D, Berardi I, Pugliese G, Fusco D, Della Salda L. Cytological, Histological and Ultrastructural Nuclear Features of Monster Cells in a Canine Carotid Body Carcinoma. Journal of Comparative Pathology. 2014 July 1;151(1):57–62.
- Rothacker TR, Pohlman L, Lin D, Andrews G. Pathology in Practice. 2020 June 1 [cited 2025 Dec 8]; Available from: https://avmajournals.avma.org/view/journals/javma/256/11/javma.256.11.1229.xml
- Handa U, Kundu R, Mohan H. Cytomorphologic spectrum in aspirates of extra-adrenal paraganglioma. J Cytology. 2014 June;31(2):79.
- Morita C, Tanaka M, Noguchi S, Shimamura S, Wada Y, Izawa T, et al. An aortic body carcinoma with sarcomatoid morphology and chondroid metaplasia in a French Bulldog. J Vet Med Sci. 2020 May;82(5):576–9.
- Wolfe HA, Thomason JD, Kumar P. Pathology in Practice. 2018 June 1 [cited 2025 Dec 8]; Available from: https://avmajournals.avma.org/view/journals/javma/252/11/javma.252.11.1355.xml
- Yamamoto S, Fukushima R, Hirakawa A, Abe M, Kobayashi M, Machida N. Histopathological and Immunohistochemical Evaluation of Malignant Potential in Canine Aortic Body Tumours. J Comp Pathol. 2013 Aug 1;149(2):182–91.
- Ecaterina S, Hodor D, Sall IM, Toma C, Tăbăran AF. Comparative exploration of the carotid body in domestic animals: morphology, physiology, histology, and pathology. Front Vet Sci. 2024 Nov 22;11:1409701.
- Teh APP, Pratakpiriya W, Hidaka Y, Sato H, Hirai T, Yamaguchi R. An atypical case of recurrent carotid body carcinoma in a young adult dog: Histopathological, immunohistochemical and electron microscopic study. J Vet Med Sci. 2017 Apr;79(4):714–8.
- Ehrhart N, Ehrhart EJ, Willis J, Sisson D, Constable P, Greenfield C, et al. Analysis of Factors Affecting Survival in Dogs With Aortic Body Tumors. Vet Surgery. 2002;31(1):44–8.
- Rancilio NJ, Higuchi T, Gagnon J, McNiel EA. Use of three-dimensional conformal radiation therapy for treatment of a heart base chemodectoma in a dog. J Am Vet Med Assoc. 2012 Aug 15;241(4):472–6.
- Pereira V de C, Rosa RB, Cony FG, Ribeiro PR, Silva EMS da, Pereira PR, et al. Neoplasms with splenic involvement in dogs at necropsy: Macroscopic presentation patterns in 262 cases. J Comp Pathol. 2025;222:20–7.
- Fontes GS, Piegols HJ, Lapsley JM, Bracha S, Selmic LE. Outcome in dogs with invasive adrenal gland tumors that did not pursue adrenalectomy. J Am Vet Med Assoc 2024;262(7)1-5.